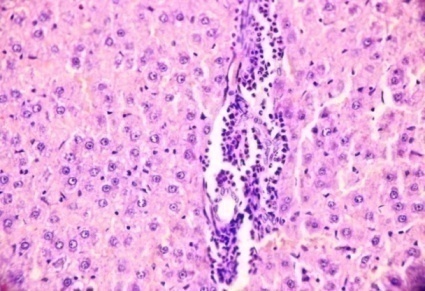

Int J Pharm Pharm Sci, Vol 6, Issue 10, ??-??Original Article
ANTIOXIDANT AND HEPATO PROTECTIVE ACTIVITY OF VARIOUS EXTRACTS OF INDIGOFERA BARBERI GAMBLE AGAINST D-GALACTOSAMINE INDUCED TOXICITY IN RATS
SRINIVASAN. N*, SATHYANARAYANA. D
Department of Pharmacy, FEAT, Annamalai University, Annamalai Nagar 608002 Tamil Nadu, India.
Email: seenu301@gmail.com
Received: 21 Jul 2014 Revised and Accepted: 25 Aug 2014
ABSTRACT
Objective: To investigate Antioxidant and Hepatoprotective activity of various extracts of Indigofera barberi Gamble against D-Galactosamine induced toxicity in rats.
Methods: Indigofera barberi Gamble is used traditionally as folk system of medicine in India for the treatment of liver diseases, and as a liver tonic. Petroleum ether (PEEIB), chloroform(CEIB) and ethanolic extracts (EEIB) of Indigofera barberi Gamble (aerial part of the plants extracts, 200mg/kg, p. o) was tested for its hepatoprotective effect against D-galactosamine induced hepatic damage in rats at a dose of (400mg/kg, i. p) to induce hepatotoxicity and Silymarin (25 mg/kg, i. p.) was administered as standard drug.
Results: The biochemical parameters of liver tissue LPO, GSH, GPX, GST, SOD and CAT values were significantly (p<0.01) altered against ethanolic extracts treatment of Indigofera barberi Gamble and were comparable with standard drug silymarin.
Conclusion: Animal pretreatment with petroleum ether and chloroform extracts of Indigofera barberi Gamble did not change above mentioned parameters significantly. The histopathological studies also substantiates the results and hence, it can be concluded from the present study that, the ethanolic extracts of Indigofera barberi Gamble has appreciable hepatoprotective potential in albino rats against D-galactosamine induced hepatic damage.
Keywords: D-Galactosamine, Silymarin, Indigofera barberi, Biochemical parameters, Ethanolic extract.
INTRODUCTION
Oxidative stress, a consequence of an imbalance of pro-oxidants and antioxidants in the organism, has been implicated in several disease states, including inflammation and liver disease. The liver, because of its role in metabolism, is exposed to many kinds of xenobiotics and therapeutic agents. Moreover, the rapidly increasing morbidity and mortality rates from liver diseases are largely attributable to the repeated chemical insult either from drug abuse or from environmental pollution[1]. Hence, there are many researchers of traditional medicines attempting to develop new drugs for hepatitis[2]. D-Galactosamine (D-GalN) induced hepatic injury in animals mimics the sequences of events in human hepatitis and is widely used in the screening of hepatoprotective drugs.
The advantage of this model is that DGalN potentiates the toxic effects of lipopolysaccharide (LPS) and produces fulminate hepatitis within a few hours. D-GalN is an amino sugar selectively metabolized by hepatocytes, which depletes the uridine phosphate pool, resulting in the inhibition of mRNA and protein synthesis [3]. This process may lead to cellular damage and inflammation, resulting in histological and biochemical picture that closely resembles viral hepatitis.
Upon stimulation with LPS, liver macrophages secrete various pro-inflammatory cytokines, leading to hepatic necrosis and decreased levels of antioxidant enzymes and the scavenging of free radicals and thus these models provides a practical tool for the evaluation of drugs and compounds that interfere with hepatic apoptosis and inflammatory liver injury [4]. Indigofera barberi is a small shrub which belongs to the family Fabaceae and is widely distributed in India. In particularly, it is used for various ailments including liver disorders and tumors, wounds, skin disease, jaundice, anthelmintic, nephroprotective and diabetes [5, 6]. However there is no report of hepatoprotective activity of Indigofera barberi has been found in literature. Therefore, the present study was planned to investigate the effect of various extracts of aerial plants of Indigofera barberi in D-GalN induced hepatic injury in Wistar rats.
MATERIALS AND METHODS
Preparation of Indigofera barberi Gamble extract
The aerial plants of Indigofera barberi Gamble were collected from the forest region of Talakona (Nelakona region) of Chitoor District, Andhra Pradesh, India, in the month of November - 2012. The plant material was identified and authenticated from the Plant Anatomy Research Centre, Chennai, Tamil Nadu, India. Shade dried whole plants were powdered to moderately coarse grade. Petroleum ether, chloroform and ethanolic extracts of aerial plants were obtained by using Soxhlet extractor. The extracts were concentrated under reduced pressure under controlled temperature (40-50ºC) using rota-vapour. Suspension of each extract was freshly prepared using 0.1% Tween 80, for experimental use.
Drugs and chemicals
Silymarin was purchased from Micro labs Ltd., Bangalore, India; Tween 80 were purchased from S. D. Fine Chemicals Ltd., Mumbai, India; D-Galactosamine (D-GalN) was purchased from Merck India, Ltd., Mumbai, India; and other solvents/reagents was of analytical grade.
Animals
The study was undertaken at the Central Animal House, Rajah Muthiah Medical College and Hospital, Annamalai University, Annamalai Nagar, in accordance with the National Institute of Health “Guide for the care and use of Laboratory Animals” (NIH, 1985). The study was approved by the Animal Ethical Committee of Rajah Muthiah Medical College and Hospital [Registration No 160/1999/ (CPCSEA) Annamalai Nagar, Tamil Nadu, India. Albino (Wistar) female rats of 180-220 gm (weighing) were used for the study and were fed with standard pellet diet and water ad libitum. As per the standard practice, the rats were acclimated 15 days before the commencement of the experiment. Animals were housed in well ventilated room (temperature 23±2oC, humidity 65-70% and 12h light/dark cycle).
Acute oral toxicity
The acute toxicity test was performed according to the Organization of Economic Co-operation and Development (OECD) guidelines 423 for testing of chemicals [17]. Female rats were used for the acute toxicity study. PEEIB, CEIB and EEIB extracts were given up to 2000 mg/kg individually, by oral route through intragastric tube and the LD50 values were calculated (OECD-423).
Experimental protocol
Rats were randomly divided into six groups of six animals each. Group I served as normal control and received normal saline 1 ml orally for 21 days. Group II served as toxic control and received normal saline 1 ml orally for 21 days. Group III were treated with 25mg/kg of Silymarin orally for 21days,GroupIV were treated with petroleum ether extract of Indigofera barberi (PEEIB) at a dose of 200mg/kg suspended in 0.1% Tween 80 through orally, Group V were treated with chloroform extract of Indigofera barberi (CEIB) at a dose of 200mg/kg suspended in 0.1% Tween 80 through orally, Group VI were treated with ethanolic extract of Indigofera barberi (EEIB) at a dose of 200mg/kg suspended in 0.1% Tween 80 through orally, Group II to group VI received D-GalN(400 mg/kg,i. p.) on 21st day. After 24 h of D-GalN administration animals in all the groups were humanely sacrificed using xylazine + Ketamine (16 + 100 mg/kg, i. m), prior to biochemical analysis, each hepatic tissue (100mg/ml buffer) was homogenized in 50 mM phosphate buffer (pH 7.0). The homogenate was then centrifuged at 10,000 rpm for 15 min and the supernatant obtained was used for biochemical analysis viz.,lipid peroxides (LPO)[7], Reduced glutathione (GSH)[8], Glutathione peroxides (GPX)[9], Glutathione-S transferase (GST)[10], Superoxide dismutase (SOD)[11] and Catalase (CAT)[12] by using Secomam semi auto analyzer and a part of tissue was subjected to histopathological studies[13].
Statistical analysis
The statistical analysis was carried out by one way analysis of variance (ANOVA) followed by NewmannKeul’s multiple range tests. The values are represented as Mean±SEM. Probability value of P <0.01 was determined to be statistically significant.
RESULTS
The LD50 value for PEEIB, CEIB and EEIB were found to be 2000mg/kg/oral body weight individually. There was no alteration in gross behavior effects visually when compared with control group animals. In liver homogenate, there was significant decrease in SOD, CAT,GSH,GST and GPx levels and increase in LPO levels was observed in animals treated with D-GalN400mg/kg (group II) as compared to the normal control group (Group I). Pretreatment with ethanolic extract of Indigofera barberi(EEIB) at a dose of 200mg/kg orally for 21 days increase the levels of above parameters like SOD, CAT,GSH,GST and GPx levels and decrease levels of LPO significantly (P<0.01) in group VI. Whereas animal’s pretreatment with petroleum ether and chloroform extracts of Indigofera barberidid not change above mentioned parameters significantly.
Silymarin pretreatment produced the significant increase in (P<0.01) Liver homogenate enzyme such as SOD, CAT, GSH, GST and GPxlevels and decrease the levels of LPO significantly (P<0.01) in group III.
Table 1: Results of the antioxidantactivity of various extracts of Indigofera barberi Gamble
| Group.
No. |
Treatment dose
(mg/Kg) |
SOD | CAT | GPx | LPO | GSH | GST |
| I | Normal control | 9.06±
0.88 |
0.190±
0.02 |
10.6±
0.86 |
106.76±
4.06 |
4.11±
0.12 |
1194±
88 |
| II | Toxic Control (DGalN) | 2.56±
0.10* |
0.010±
0.01* |
2.58±
0.12* |
160.82±
7.92* |
2.04±
0.14* |
629±
56* |
| III | Treatment Silymarin25mg/kg | 7.85±
0.66** |
0.090±
0.02** |
7.82±
0.59** |
112.80±
5.05** |
4.23±
0.09** |
1158±
45** |
| IV | Treatment
PEEIB 200mg/kg |
3.18±
0.15 |
0.016±
0.01 |
3.15±
0.22 |
149.42±
6.25 |
3.49±
0.12 |
720±
4.22 |
| V | Treatment
CEIB 200mg/kg |
2.98±
0.14 |
0.018±
0.02 |
3.23±
0.30 |
158.26±
6.60 |
3.54±
0.42 |
711±
6.47 |
| VI | Treatment
EEIB 200mg/kg |
7.02±
0.60** |
0.080±
0.02** |
7.06±
0.20** |
126.80±
5.38** |
4.18±
0.11** |
1118±
22** |
Values expressed: Levels of lipid peroxides (LPO) – nmolmalondialdehyde released/mg protein; Reduced glutathione (GSH) – μmol (oxidized min-1 mg-1 protein);Glutathione peroxidise (GPx) – nmol (oxidized min-1 mg-1 protein);Glutathione-S transferase (GST)- μmol (1-chloro-2, 4-dinitrobenzene conjugate formed min-1 mg-1 protein);Catalase (CAT) – nmol (H2O2 decomposed min-1 mg-1);Superoxide dismutase (SOD) - (one unit of the SOD activity is the amount of protein required to give 50% inhibition of epinephrine autoxidation). Values are expressed as Mean ± SEM. * – values are significantly different from Normal control at P< 0.01.** – values are significantly different from Toxic control (G2) at p< 0.01.
Histopathological observations
Histology of liver sections of normal control animals (Group I) showed normal liver architecture with were brought out the central vein, were preserved cytoplasm and prominent nucleus and nucleolus (Fig. 1). The liver sections of D-GalN treated animals (Group II) showed hepatic cells toxicity characterized by inflammatory cell collection, scattered inflammation across liver parenchyma, focal necrosis and swelling up of vascular endothelial cells (Fig. 2). Silymarin (Group-III) exhibited protection from D-GalN induced changes in the liver (Fig. 3). Pretreatment with ethanolic extract of Indigofera barberi (EEIB) at a dose of 200mg (group VI) appeared to significantly prevent the D-GalN toxicity as revealed by the hepatic cells with were preserved cytoplasm and pretreatment also caused marked decrease in inflammatory cells (Fig. 6).
DISCUSSION
The LD50 value for PEEIB, CEIB and EEIB was found to be 2000mg/kg/oral body weight individually. In the present study treatment of rats with D-GalN elicited a significant increase in the LPO. EEIB treatment prevented the increase in LPO indicating the protective effect of EEIB against lipid per oxidation. Moreover, it has been observed that chronic EEIB significantly decreased lipid per oxidation and increased endogenous antioxidants such as SOD, CAT,GSH,GST and GPx, Since administration of EEIB prevented the hepatic GPx depletion, it appears that the protective effect of EEIB involves the maintenance of antioxidant capacity in protecting the hepatic tissue against oxidative stress. Excessive production in hydroxyl radicals in the blood and liver has previously been demonstrated in rats, indicating that circulating pro-inflammatory cytokines, such as TNF-α, which triggers hepatic injury, were increased, at least in part, by a free-radical mediated apoptosis mechanism [14]. In this study, treatment with EEIB probably ameliorated oxidative liver injury through its antioxidant effect which further alleviated hepatic injury as shown as biochemical findings. In addition, several reports showed that hepatic antioxidant defense system associated with antioxidant enzymes such as SOD, CAT, GSH, GST and GPx, are disrupted in D-GalN treated rat. Accordingly as D-GalN induced-hepatotoxicity has striking resemblance to the human viral hepatitis [15], the present study confirms the hepatoprotective efficacy of EEIB against D-GalN induced hepatitis in rats.
 |
 |
 |
 |
|
 |
Fig. 1: Liver section of normal control rats showing (a): Normal liver lobular architecture with well brought out central vein and prominent nucleus and nucleolus; (b):D-GalN (400mg/kg. i. p) treated rats showing severe toxicity with congested blood vessels with inflammatory cell collection and endothelial cell swelling; (c): Treated with Silymarin 25mg/kg (p. o)+D-GalN (400mg/kg) showing only a few inflammatory cells around portal tract; (d): Treated with pet ether extract of Indigofera barberi (200mg/kg) + D-GalN (400mg/kg) showing only slight inflammation; (e): Treated with chloroform extract of Indigofera barberi (200 mg/kg) + D-GalN (400 mg/kg) showing only slight inflammation; (f): Treated with ethanolic extract of Indigofera barberi (200mg/kg) + D-GalN(400 mg/kg)showing slight inflammation.
D-Galactosamine is reported to produce intensive inflammatory infiltration in the liver parenchyma and peripheral areas[16]. In our study also D-GalN administration showed severe hepatotoxicity with heavy infiltration of inflammatory cells around portal tract and in the liver parenchymal cells. Pre-treatment with EEIB and Silymarin for 21 days protected the rat livers from D-GalN induced histopathological change.
CONCLUSION
These observations make more evident that Indigofera barberi gamblei s one of the promising herbal drugs for improving defense mechanisms in the physiological systems against oxidative stress caused by the D- Galactosamine. The probable action could be due to stabilizing the hepatocellular membrane, inhibiting neutrophil infiltration into the liver cells, preventing the process of lipid peroxidation, preventing inactivation of antioxidant enzymes. It might be used in the treatment of viral hepatitis.
CONFLICT OF INTERESTS
Declared None.
REFERENCES
- Sambrekar SN, Patil PA, Kangralkar VA. Protective activity of Mussaenda frondosa leaf extracts against paracetamol induced hepatic damage in wistar rats. J Pharm Res 2010;3(4):711-3.
- Ravikumar V, Shivashangari KS, Devaki T. Hepatoprotective activity of Tridax procumbens against D-Galactosamine/ lipopolysaccharide-induced hepatitis in rats. J Ethnopharmacol 2005;101(1-3): 55–60.
- Wu YL, Lian LH, Jiang YZ, Nan JX. Hepatoprotective effects of Salidroside on fulminant hepatic failure induced by D-Galactosamine and lipopolysaccharide in mice. J Pharm Pharmaco 2009;61(10):1375–82.
- Morrison DC, Danner RL, Dinarello CA, Munford RS, Natanson C, Pollack M, et al. Bacterial endotoxins and pathogenesis of gram-negative infections: current status and future direction. J Endotoxin Res 1994;1(2):71–83.
- Madhavachetty K, Sivaji K, Tulsirao K. Flowering parts of Chittoor district, Andhra Pradesh, India. 1st Edition. Students offset printers;2008. p. 91-2.
- Gamble JS. Flora of the Presidency of Madras, Vol. I, Published under the authority of the secretary of state for India in council;2001. p. 309-10.
- Ohkawa H, Onishi N, Yagi K. Assay for lipid peroxides in animal tissue by Thiobarbituric acid reaction. Anal Biochem 1979;95:351-8.
- Habig WH, Pabst MJ, Jackoby WB. Glutathione-S transferases: the first enzymatic step in mercapturic acid formation. J Biol Chem 1974;249:7130-9.
- Hochstein P, Utley H. Hydrogen peroxide detoxication by glutathione peroxidase and catalase in rat liver homogenates. Molecular Pharmaco 1968;16:574–9.
- Moron MS, Dipieree JW, Mannerwik B. Levels of glutathione, glutathione reductase and glutathione-S-transferase activities in rat lung and liver. Biochimica Biophysica Acta 1979;582 (1):67–78.
- Oynagui Y. Reevaluation of assay methods and establishment of kit for superoxide dismutase activity. Anal Biochem 1984;142(2):290–6.
- Bergmeyer HU. Measurement of catalase activity. Biochemische Zeitschrift 1955;327:255–96.
- Millard PR. Essential Histopathology, Blackwell Scientific Publications, London; 1990. p. 1-337.
- Drotman RB, Lawhorn GT. Serum enzymes are indicators of chemical induced liver damage. Drug Chemical Toxicology 1978;1(2):163-71.
- Frei B, Hidgon JV. Antioxidant activity of tea polyphenols in vivo: evidence from animal studies. J Nut 2003;133(10):3275-84.
- El-Mofty SK, Scrutton MC, Serroni A, Nicolini C, Farber JL. Early, reversible plasma membraneinjury in galactosamine-induced liver cell death. Am J Pathology 1975;79(3):579–96.
- The OECD Guideline for Testing of Chemical: 423-Acute Oral Toxicity – Acute Toxic Class Method. OECD, Paris; 2001. p. 1–14.